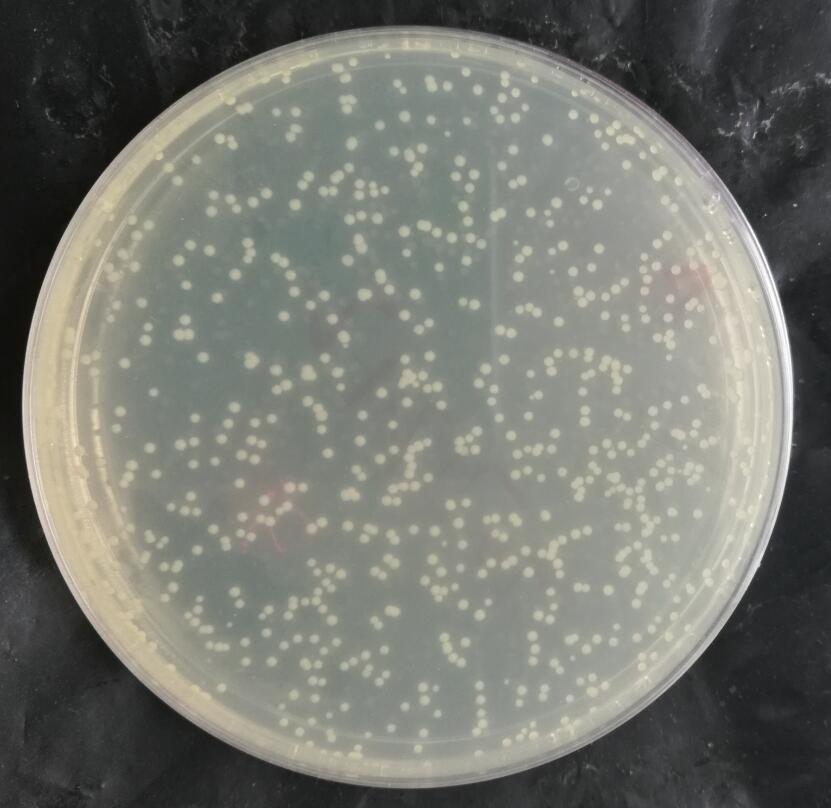
CICC22376 球形芽孢杆菌染菌载体（玻片）

相关产品推荐更多 >
万千商家帮你免费找货
0 人在求购买到急需产品
- 详细信息
- 技术资料
- 库存:
10
- 保质期:
详见説明
- 供应商:
上海晶风生物
CICC22376 球形芽孢杆菌染菌载体(玻片)微生物的生长伴随着一系列生理指标发生变化,与生长量相平行的生理指标很多,它们可作为生长测定的相对值。
1、测定含氮量:
大多数细菌的含氮量为干重的12.5%,酵母为7.5%,霉菌为6.0%。根据含氮量×6.25,即可测定粗蛋白的含量。含氮量的测定方法有很多
2、测定含碳量:
将少量(干重0.2-2.0 mg)生物材料混入1毫升水或无机缓冲液中,用2毫升2%的K2Cr2O7溶液在100 0C下加热30分钟后冷却。加水稀释至5毫升,在580nm的波长下读取吸光光度值,即可推算出生长量。需用试剂做空白对照,用标准样品做标准曲线。
3、还原糖测定法:
还原糖通常是指单糖或寡糖,可以被微生物直接利用,通过还原糖的测定可间接反映微生物的生长状况,常用于大规模工业发酵生产上微生物生长的常规监测。
4、氨基氮的测定:
方法是,离心发酵液,取上清液,加入甲基红和盐酸作指示剂,加入0.02N的NaOH调色至颜色刚刚褪去,加入底物18%的中性甲醛,反应数刻,加入0.02N的使之变色,根据NaOH的用量折算出氨基氮的含量。根据培养液中氨基氮的含量,可间接反映微生物的生长状况。
5、其他生理物质的测定:
P,DNA,RNA,ATP,NAM(乙酰胞壁酸)等含量以及产酸,产气,产CO2(用标记葡萄糖做基质),耗氧,黏度,产热等指标, 都可用于生长量的测定。也可以根据反应前后的基质浓度变化,最终产气量,微生物活性三方面的测定反映微生物的生长。
CICC22376 球形芽孢杆菌染菌载体(玻片)相关菌种衰退的根本原因是有关基因的负突变。如果控制产量的基因发生负突变,则表现为产量下降;如果控制孢子生成的基因发生负突变,则产生孢子的能力下降。菌种在移种传代过程中会发生自发突变。虽然自发突变的几率很低(一般为10-6~10-9),尤其是对于某一特定基因来说,突变频率更低。但是由于微生物具有极高的代谢繁殖能力,随着传代次数增加,衰退细胞的数目就会不断增加,在数量上逐渐占优势,最终成为一株衰退了的菌株。
此外,菌种衰退还有以下几种原因:
1、表型延迟造成菌种衰退,表型延迟现象也会造成菌种衰退。如,在诱变育种过程中,经常会发现某菌株初筛时产量较高,进行复筛时产量却下降了。
2、质粒脱落导致菌种衰退,质粒脱落导致菌种衰退的情况在抗生素生产中较多,不少抗生素的合成是受质粒控制的。当菌株细胞由于自发突变或外界条件影响(如高温),致使控制产量的质粒脱落或者核内DNA和质粒复制不一致,即DNA复制速度超过质粒,经多次传代后,某些细胞中就不具有对产量起决定作用的质粒,这类细胞数量不断提高达到优势,则菌种表现为衰退。
3、连续传代,连续传代是加速菌种衰退的一个重要原因。一方面,传代次数越多,发生自发突变(尤其是负突变)的几率越高;另一方面,传代次数越多,群体中个别的衰退型细胞数量增加并占据优势越快,致使群体表型出现衰退。
4、不适宜的培养和保藏条件,不适宜的培养和保藏条件是加速菌种衰退的另一个重要原因。不良的培养条件如营养成分、温度、湿度、pH值、通气量等和保藏条件如营养、含水量、温度、氧气等,不仅会诱发衰退型细胞的出现,还会促进衰退细胞迅速繁殖,在数量上大大超过正常细胞,造成菌种衰退。
CICC22376 球形芽孢杆菌染菌载体(玻片)产品用途:主要用于阳性对照反应和培养基质量控制等实验
以下为该产品部分相关知识,更多产品,更多知识可以咨询我们。
培养基的保质期各不相同。不同的标准中均有明确规定了保存的条件和保质期。培养基应保存在防止其成分发生变化的环境下,即应避光、干燥保存;如有必要,用保存于2℃~8℃冰箱中,或依据培养基要求的储存条件进行保存。除标准规定或保质期验证实验的结果表明有较长的保质期外,通常平板保存不超过2周~4周,三角瓶和试管的保存不超过3个月~6个月。除标准规定或保质期验证实验的结果表明有较长的保质期外,含有不稳定添加成分的培养基应即配即用。对发生化学反应或含有不稳定物质的固体培养基也应即配即用,不可二次融化。实验室应对贮存培养基的有效期进行规定。观察培养基颜色变化,是否有蒸发/脱水情况,是否有微生物生长。当培养基发生这类变化时,应停止使用。在使用和进一步加热前,应事先将培养基放置到室温。使用商品化脱水合成培养基制备培养基时,应严格按照厂商提供的使用说明配置。记录所有相关数据,如质量/体积、pH、制备日期、灭菌条件和制备人员等。使用各别成分制备培养基时,应按照配方准确配制,记录所有细节信息,如:培养基名称和类型及试剂级别、每个成分物质含量、制造商、批号、pH、培养基体积(分装体积)、无菌措施(包括实施的方式、温度及时间)、配置日期、人员等,以便溯源。
CICC22376 球形芽孢杆菌染菌载体(玻片)相关琼脂培养基的融化:培养基放到沸水浴中或采用其他有相同效果的方法(如高压锅中的蒸汽)融化。经过高压灭菌的培养基尽量减少重新加热的时间,避免过度加热。培养基融化后立即移开,室温静置片刻(约2min),以免玻璃容器发生破裂。融化后的培养基放人47℃~50℃恒温水浴锅中保温,冷却到47℃~50℃所需的时间取决于培养基的类型、体积和在水在锅里的分装量。融化后的培养基应尽快使用,放置时间一般不超过4h。剩余的培养基凝固后不得再次融化使用。特别是灵敏性培养基,应根据相关标准,缩短融化后放置的时间。将琼脂培养基倒人类似检测培养基使用的独立容器中,插入温度计,记录并保存琼脂的融化、温度。加入样品的培养基应将温度调节到44℃~47℃,或按照相关标准调节温度。水浴保温的顶层培养基中依次加入测试增菌液0.1 mL(需活化时另加10%S9混合液o.5 mL),混匀,迅速倾入底层培养基上,转动平板,使顶层培养基在底层分布均匀。平放固化后取无菌滤纸片(直径约为6 mm),小心放在已固化的顶层培养基的适当位置上,用移液器取适量受试物(如10μL),点在纸片上,或将少量固体受试物结晶加到纸片或琼脂表面;37℃培养48 h观察结果。
更多产品详情请咨询我们:CICC22376 球形芽孢杆菌染菌载体(玻片)
风险提示:丁香通仅作为第三方平台,为商家信息发布提供平台空间。用户咨询产品时请注意保护个人信息及财产安全,合理判断,谨慎选购商品,商家和用户对交易行为负责。对于医疗器械类产品,请先查证核实企业经营资质和医疗器械产品注册证情况。
 技术资料
技术资料暂无技术资料 索取技术资料









